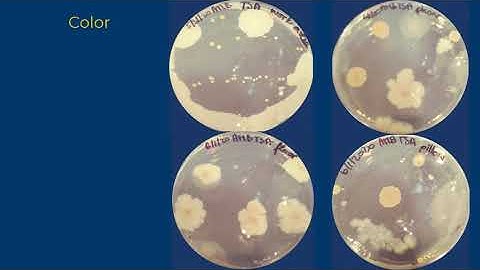
Colony Morphology
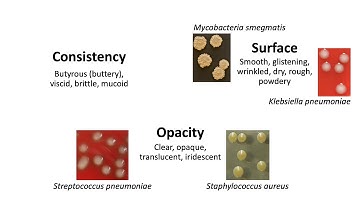
Level 2 Microbiology & Immunology | Microbiological Examination of River Water (Colony Morphology)
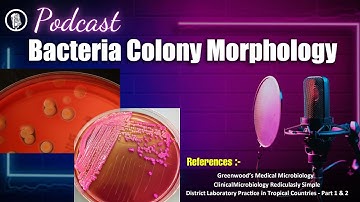
Bacteria Colony Morphology | A Complete Guide Podcast | Listen & Learn

⬇ DOWNLOAD NOW
Kalau muncul iklan pop-up, tutup lalu klik tombol kembali
Download lagu Bacterial Colony Morphology with Live Examples secara gratis hanya untuk keperluan promosi. Dukung artis favorit kamu dengan membeli musik original di iTunes atau platform resmi lainnya.
 Bacterial Colony Description
Bacterial Colony Description
Colony Morphology
Colony Morphology
Level 2 Microbiology & Immunology | Microbiological Examination of River Water (Colony Morphology)
Level 2 Microbiology & Immunology | Microbiological Examination of River Water (Colony Morphology)
 " Bacteria Colony Morphology "🧫🔬 Identification Training - Quiz 1/10
" Bacteria Colony Morphology "🧫🔬 Identification Training - Quiz 1/10
Bacteria Colony Morphology | A Complete Guide Podcast | Listen & Learn
Bacteria Colony Morphology | A Complete Guide Podcast | Listen & Learn
 Staphylococcus Aureus Growth & Colony Morphology
Staphylococcus Aureus Growth & Colony Morphology
 Colony morphology of Bacteria Demo
Colony morphology of Bacteria Demo
 BACTERIAL COLONY MORPHOLOGY / CHARACTERISTICS | Microbiology basics | FY BSc practical series
BACTERIAL COLONY MORPHOLOGY / CHARACTERISTICS | Microbiology basics | FY BSc practical series